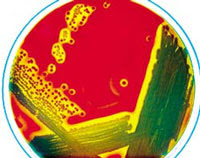

1)Indole
-measure the ability to hydrolyse and deaminate tryptophan
-Klesiella-enterobacter-salmonella-serratia are mostly negative
-positive-red colour
2)Methyl red
-methyl red, a pH indicator with a range between 4.4(red) and 6.0(yellow)
-only species that produce suffiicient acids can maintian the pH at below4.4 against the buffer system of the test medium
-most species of Enterobacteriaceae produce strong acids. Enterobacter-serratia do not produce enough acids
-positive-stable red colour in the surface layer of the medium
3)Voges-proskauer reaction test
-this test is based on the conversion of acetoin to a red coloured complex through the action of KOH, atmospheric 02 and alpha napthol
-Klesiella-enterobacter-serratia is able to perform this pathway
-red colour at the surface of the medium after 15 mins following the addition of reagents
4)Citrate utilisation test
-some bacteria have the ability to utilize citrate as the sole carbon sourc and turn the medium allkaline due to production of ammonia
-Escherichia-Edwardisella-shigella-salmonella cannot utilise citrate as the sole source of carbon
-positive-from colour green to blue
5)Urease test
-some species posses the enzyme urease and able to hydrolyze urea with the release of ammonia and carbon dioxide
-this is used mainly to differentiate urease positive Proteus species from other member of Enterobacteriaceae
-positive-yellowish orange to pink
Biochemical tests for gram positive bacteria
1)Oxidase test
-this is to differentiate those that possess the enzyme cytochrome oxidase c from those that lack of the enzyme
-useful in screening for bacteria species which belong to the Enterobacteriaceae or the Pseudomonas genus
-positive-development of purple colour
2)Coagulase test
-the coagulase test is used to differentiate staphylcoccus aures from other staphylcoccus species
-positive-clot forms